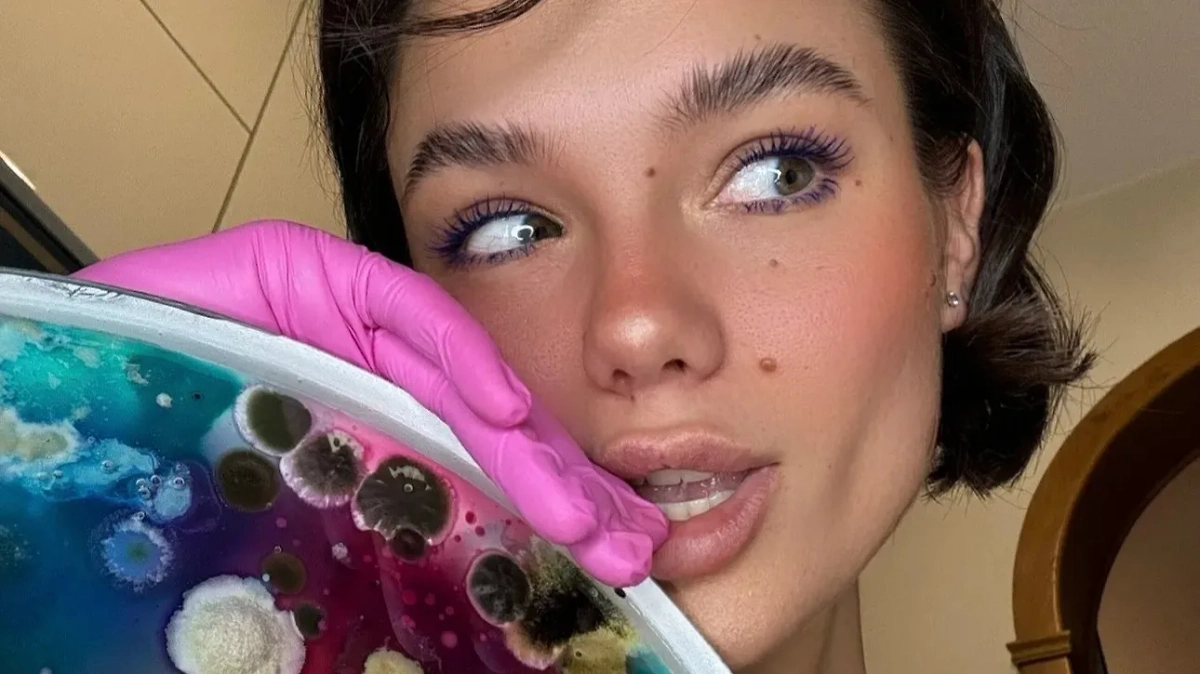
Фото © Instagram (признан экстремистской организацией и запрещён на территории Российской Федерации) / dashaplesen

«Споры об искусстве»: Как Даша Плесень создаёт картины на стыке красоты и отвращения, зарабатывая по 800 тысяч с каждой
Московская художница собирает микробиом людей и превращает его в уникальные портреты из живой плесени — искусство на стыке науки, тела и философии. Life.ru узнал всё об этом удивительном искусстве.

Коллаж © Life.ru. Обложка © Instagram (признан экстремистской организацией и запрещён на территории Российской Федерации) / dashaplesen
Её холст — чашка Петри, краски — споры плесени, а модели — бактерии, обитающие на человеческом теле. Московская художница Дарья Фёдорова, известная под псевдонимом Даша Плесень, превратила микромир в искусство и зарабатывает на этом тысячи долларов. Life.ru поговорил с художницей и узнал, что такое биологический портрет и как естественный рост микроорганизмов может раскрыть человеческую сущность.
От мечты о хирургии к микромиру

Фото © Instagram (признан экстремистской организацией и запрещён на территории Российской Федерации) / dashaplesen
Дарья Фёдорова родилась в Москве, ей 28 лет. Она называет себя художником, фотографом, концептуальным мыслителем — и просто человеком, который наслаждается жизнью. Идея создавать портреты из плесени пришла к Даше далеко не сразу. В детстве она мечтала стать хирургом. Бабушка, офтальмохирург, привила внучке интерес к медицине. Вместо сказок девочка зачитывалась хирургическими атласами и считала человека величайшей загадкой.
Однако в подростковом возрасте её жизнь пошла по другому сценарию. Во время эмоционально непростого периода Дарья случайно попала на день открытых дверей в Британскую высшую школу дизайна — и словно нашла своё место в мире. «Я попала в рай — рай для таких, как я: сумасшедших, свободных, креативных», — говорит девушка.
Посмотреть видео можно на основной версии сайта
Во время написания дипломной работы Даша искала нечто уникальное. Она медитировала, вместо того чтобы шерстить Интернет, и вдруг увидела образ чашек Петри, в которых можно было бы визуализировать микромир, окружающий человека каждый день. Так в 2015 году началось её необычное художественное увлечение.
Откуда появился псевдоним «Плесень»?

Фото © Instagram (признан экстремистской организацией и запрещён на территории Российской Федерации) / dashaplesen
Однажды, выйдя со своей первой персональной выставки, художница поняла, что ей необходим псевдоним, — так родилась Даша Плесень. «Да, я — Даша Плесень. И теперь так всегда будет. И пофиг, кто чё думает», — рассказывает художница.
Девушка отмечает, что на первый взгляд отталкивающий псевдоним стал её брендом. Он звучит звонко, странно, противоречиво — и мгновенно вызывает интерес. Люди постоянно переспрашивают: «Что-что? Плесень?» — и для Даши это лишь начало увлекательного разговора о глубинных слоях реальности.
Что такое биопортрет?
Посмотреть видео можно на основной версии сайта
Работы Даши — это искусство, которое невозможно воспроизвести дважды. Художница собирает микробиом человека: слепки с кожи, из ушей, носа, рта, между пальцами. Затем эти микроорганизмы «расцветают» на питательной среде, создавая неповторимый живой рисунок.
«Биопортрет — это не просто художественное изображение. Это след человека, событие, атмосферы, воздух. Уникальный отпечаток, который невозможно воссоздать», — объясняет художница.
Фото © Instagram (признан экстремистской организацией и запрещён на территории Российской Федерации) / dashaplesen
Почему именно плесень? Художница объясняет, что плесень живёт с нами всегда — на коже, в носу, под мышками. Даша работает с плесенью так же, как другие художники работают с маслом или глиной. Она экспериментирует с разными техниками: свободным засеиванием, культивацией воздуха, взаимодействием с поверхностями. Например, она может гулять с чашкой Петри по городу — и микроорганизмы сами «прилипают» к среде. В этом для неё скрыта философия: «Если дать человеку благоприятную среду — он тоже расцветёт».

Фото © Instagram (признан экстремистской организацией и запрещён на территории Российской Федерации) / dashaplesen
Каждое произведение — это коллаборация с микроорганизмами. Девушка вручную создаёт холст из питательной среды, добавляет пигменты, глиттер, косметику, буквы, геометрические формы. И дальше остаётся только ждать — от двух-трёх недель до двух месяцев: питательная среда быстро застывает, пигменты ведут себя непредсказуемо, плесень может заразиться другими микроорганизмами, и тогда приходится начинать всё заново.
Кто платит за картины или платья из плесени?

Фото © Instagram (признан экстремистской организацией и запрещён на территории Российской Федерации) / dashaplesen
Стоимость биопортрета у девушки начинается от 10 тысяч долларов (это примерно 800 тысяч рублей). Среди заказчиков — биотехнологические компании, косметические бренды, музыкальные группы, дизайнеры, коллекционеры. Всех их объединяет одно: желание заполучить не просто картину, а концептуальный объект с глубинным смыслом.
«Мои заказчики — не просто коллекционеры. Это люди, готовые смотреть шире, видеть искусство как часть своего внутреннего мира и личной философии», — делится Даша.

Фото © Instagram (признан экстремистской организацией и запрещён на территории Российской Федерации) / dashaplesen
Её самая дорогая работа обошлась заказчику в 50 тысяч долларов. Это была серия биопортретов семьи, их дома и домашних животных. По словам девушки, их интересовал не просто арт, а способ увековечить своё существование через микромир. «Часто заказчики просят анонимность — вокруг темы микроорганизмов много стигмы. Люди боятся, что кто-то увидит их «болезни», «грязь». Хотя на самом деле всё совсем не так. Это просто жизнь», — рассказывает художница.
Искусство как перформанс

Фото © Instagram (признан экстремистской организацией и запрещён на территории Российской Федерации) / dashaplesen
Иногда процесс создания портретов превращается в настоящий перформанс. Например, однажды Даша покрыла себя лоскутами живой плесени для фотосессии: «Я была вся в вазелине, пахла шампиньонами. Это был проект на грани дозволенного. Но в этом и есть настоящее искусство — в смелости эксперимента», — вспоминает художница.

Фото © Instagram (признан экстремистской организацией и запрещён на территории Российской Федерации) / dashaplesen
В другом случае художница выращивала плесень прямо на чехле от iPhone, сохраняя при этом фирменные цвета. «Работа с живой материей всегда стресс. Но именно в таких проектах рождается истинный художник», — уверена она.
А что дальше? Как развивать бизнес, построенный на плесени?

Фото © Instagram (признан экстремистской организацией и запрещён на территории Российской Федерации) / dashaplesen
В ближайших планах Даши — масштабная персональная выставка. Она мечтает собрать все свои работы за 10 лет — от живописи и скульптуры до интерактивных чашек Петри, которые будут «расти» в реальном времени.
«Я хочу установить большую скульптуру в общественном пространстве, к которой люди смогут прикасаться, оставляя свои микроследы. Из этих следов будет формироваться живой биопортрет человечества — микробиологический, чувственный, настоящий», — рассказывает она.

Фото © Instagram (признан экстремистской организацией и запрещён на территории Российской Федерации) / dashaplesen
Кроме того, девушка планирует расширяться в фэшен-область: создавать капсульные коллекции одежды, предметы интерьера, промдизайна и даже технологичные массажёры или интерактивные объекты для дома. А до этого Life.ru рассказывал, кто такие «друзья на час» и как они спасают людей в Сети. И как россиянки целый час стояли на гвоздях, чтобы не только побить мировой рекорд, но и донести очень важную мысль. И, конечно, прочитайте историю Романа — фотографа без рук, который живёт ярче, чем мы все. И его снимки стоит увидеть каждому! Такой талант...




